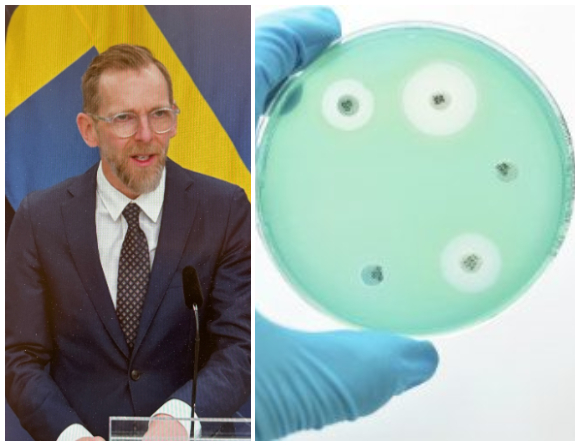
”Vi behöver kämpa för att behålla nuläget”
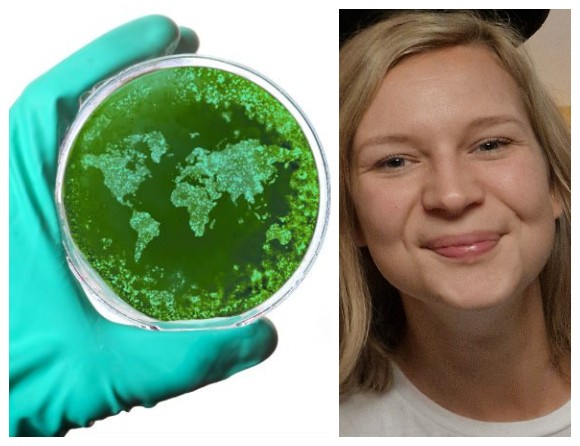
”Jag tror vi kan vända utvecklingen tillsammans”

Antibiotikakrisen
Folkhälsomyndigheten får nytt uppdrag att säkra antibiotikatillgången
Regeringen har beslutat att ge Folkhälsomyndigheten i uppdrag att fortsätta arbetet med att trygga Sveriges tillgång till viktiga antibiotika.
11 jun 2026, kl 14:13
Umeåforskare: Kan bli ett genombrott i kampen mot antibiotikaresistens
Forskare vid bland annat Umeå universitet har utvecklat en ny typ av substanser, kallade TriPcider, som kan angripa resistenta bakterier på ett helt nytt sätt. Upptäckten, som nyligen publicerats i tidskriften Science Advances,...
20 maj 2026, kl 15:36
Stor osäkerhet kring antibiotika och kosttillskott
En ny undersökning visar att många svenskar saknar kunskap om hur antibiotika påverkas av kosttillskott, livsmedel och andra läkemedel. Experter varnar för att felaktig användning kan bidra till ökad antibiotikaresistens.
12 maj 2026, kl 12:16
Antibiotika kan påverka tarmfloran i åratal
Behandling med vissa antibiotika förändrar sammansättningen av bakterier i tarmen länge efteråt.
11 mar 2026, kl 10:05
Tandläkare i Skåne skriver ut mest antibiotika
Tandvården behöver stärka arbetet mot antibiotikaresistens, enligt en ny rapport.
5 feb 2026, kl 09:27
Antibiotika på recept minskade förra året
Förskrivningen av antibiotika verkar nu åter ha vänt nedåt på allvar efter uppgången efter pandemin.
27 jan 2026, kl 10:51
Manar till försiktighet med doxy-PEP
Dagen-efter-antibiotika mot sexuellt överförd smitta kan påskynda utvecklingen av antibiotikaresistens konstaterar ECDC i nya riktlinjer.
20 jan 2026, kl 10:20
”Fortsatt svensk minskning av antibiotika är möjlig”
Högförskrivare kan minska sin förskrivning utan att det påverkar patientsäkerheten, visar en ny avhandling.
26 nov 2025, kl 10:39
Stora variationer i vår syn på antibiotikaresistens
Människors syn på antibiotikaresistens skiftar kraftigt från stark oro till "det berör inte mig", visar en Novusstudie.
19 nov 2025, kl 09:32
Avloppsvatten är sällan grogrund för resistens
Forskare i Göteborg ledde en global studie som ger ny kunskap om var antibiotikaresistens uppstår.
18 nov 2025, kl 09:35
”Vi behöver kämpa för att behålla nuläget”
Socialminister Jakob Forssmed presenterade i dag den nya svenska strategin mot antimikrobiell resistens.
17 nov 2025, kl 11:53
”Jag tror vi kan vända utvecklingen tillsammans”
Evelina Dannert grundade föreningen som hon själv ville gå med i och som inte fanns; Unga mot multiresistens.
7 nov 2025, kl 10:04
Nytt om antibiotikaval mot urinvägsinfektion hos män
En ny registerstudie visar att det nästan alltid går lika bra att använda smalspektrumantibiotika mot UVI hos män.
28 okt 2025, kl 09:24
”Vi slänger otroliga mängder läkemedel”
Att tvingas kassera stora mängder läkemedel är en av de miljöfrågor som oroar apoteksmedarbetare mest.
16 okt 2025, kl 09:35
Antibiotikaforskning får femårigt stöd
Centrum för antibiotikaresistensforskning, Care, i Göteborg får ett långsiktigt anslag av en privat stiftelse. Anslaget kommer att bidra till nya satsningar.
15 okt 2025, kl 08:56
Ny WHO-studie: Var sjätte bakterieinfektion resistent
Världshälsoorganisationen, WHO, varnar för fortsatt snabb ökning av antibiotikaresistens världen över.
14 okt 2025, kl 08:40